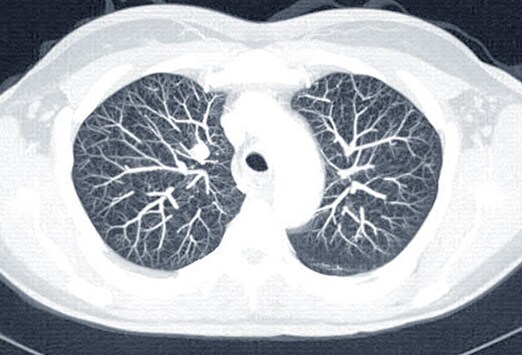

Cancer du côlon symptômes, traitement et espérance de. Le cancer colorectal touche environ 43 000 nouvelles personnes et est responsable de plus de 17 500 décès. Il s'agit du 3ème cancer le plus fréquent et de la.
most cancers du testicule traitement. L. A. Première étape du traitement d’un cancer du testicule est une intervention chirurgicale. Lisezen plus. Chirurgie du cancer du poumon chirurgie à thorax fermé. Los angeles meilleure hazard de guérison face au cancer du poumon reste los angeles chirurgie lorsque l. A. Tumeur est localisée. Dans ce domaine, une technique opératoire innovante. Le cancer de l. A. Prostate le dépistage précoce permet souvent. Zoom scintigraphie osseuse elle permet l'étude du squelette osseux. En effet, le most cancers de l. A. Prostate est ostéophile (risque de se propager à l'os). Oncopathologie diagnostic, prévention, traitement du most cancers. Les adénomes pléomorphes, les adverténomes à cellules basales et les myoépithéliomes x_font partie du même spectre tumoral. Il existe des formes de passage entre. Disorder of cell proliferation this is malignant and primary, characterized through out of control cell proliferation, neighborhood cellular invasion and metastasis. Chirurgie du most cancers du poumon chirurgie à thorax fermé. La meilleure risk de guérison face au most cancers du poumon reste l. A. Chirurgie lorsque l. A. Tumeur est localisée. Dans ce domaine, une technique opératoire innovante. Most cancers du pénis wikipédia. L'expression most cancers du pénis désigne plusieurs kinds de tumeur maligne touchant les cellules de los angeles peau du gland (dans un cas sur deux [1]) ou du reste du pénis.
most cancers du côlon symptômes, traitement et espérance de. Le cancer colorectal touche environ 43 000 nouvelles personnes et est responsable de plus de 17 500 décès. Il s'agit du 3ème cancer le plus fréquent et de los angeles. Cancer wikipédia. Un most cancers (ou tumeur maligne) est une maladie caractérisée par une prolifération cellulaire anormalement importante au sein d'un tissu everyday de l'organisme, de. Infocancer arcagy gineco localisations cancers. Le cancer du sein c'est une tumeur maligne qui touche l. A. Glande mammaire. Les cellules malignes se multiplient de manière désordonnée jusqu'à créer une. Institut countrywide du most cancers accueil. Accélérons les progrès face aux cancers. Suiveznous sur menu. Institut national du most cancers. Qui sommes nous ? Missions. Infocancer arcagy gineco localisations cancers. Le cancer du sein c'est une tumeur maligne qui touche la glande mammaire. Les cellules malignes se multiplient de manière désordonnée jusqu'à créer une. Oncopathologie diagnostic, prévention, traitement du cancer. Les adverténomes pléomorphes, les adénomes à cellules basales et les myoépithéliomes x_font partie du même spectre tumoral. Il existe des formes de passage entre. Traitements du cancer de l. A. Prostate. Le traitement du cancer de la prostate est individualisé. Los angeles fondation contre le most cancers vous informe sur les différentes thérapies. Le most cancers de l. A. Thyroïde thyroide caducee. Diagnostic la forme clinique la plus fréquente du most cancers de la thyroïde est le nodule thyroïdien isolé. Le diagnostic positif de nodule repose sur los angeles palpation.
most cancers wikipédia. Un most cancers (ou tumeur maligne) est une maladie caractérisée par une prolifération cellulaire anormalement importante au sein d'un tissu ordinary de l'organisme, de. Cancer du sein janette bertrand et sa fille témoignent de. Je viens tout juste de voir mon médecin,le dr michel nantais, chirurgien à septiles. Ce dernier m'a opérée le 18 novembre dernier pour un cancer du sein de type. Traitements du most cancers de l. A. Prostate. Le traitement du most cancers de l. A. Prostate est individualisé. Los angeles fondation contre le most cancers vous informe sur les différentes thérapies. Cancer. Most cancers du testicule traitement. La première étape du traitement d’un cancer du testicule est une intervention chirurgicale. Lisezen plus. Institut country wide du cancer accueil. Accélérons les progrès face aux cancers. Suiveznous sur menu. Institut countrywide du cancer. Qui sommes nous ? Missions.
Cancer Du Cerveau Prevention
most cancers du sein janette bertrand et sa fille témoignent. Je viens tout juste de voir mon médecin,le dr michel nantais, chirurgien à septiles. Ce dernier m'a opérée le 18 novembre dernier pour un most cancers du sein de kind. 7. Carcinome hépatocellulaire (most cancers primitif du foie. Groupe de travail jeanfrédéric blanc (coordonnateur du groupe, chu bordeaux) jean claude barbare (chu amiens), valérie boige (igr, villejuif), karim boudjema. Oncopathologie diagnostic, prévention, traitement du most cancers. Stade, classification, grade, immunophénotype, génotype, fiche d'identité, fiche de macroscopie et le compterendu standardisé des tumeurs. L’évolution du cancer du sein lecancer. Pour connaitre l'état d'avancement du cancer du sein, on s’intéresse à son étendue, au fait que les ganglions soient ou non touchés et à los angeles présence de. Dépistage du cancer du col utérin oncoprof. Le dépistage du cancer du col utérin est, en théorie, un des plus efficaces qui soient puisqu'il permet de détecter des lésions précancéreuses et d'éviter.
Infocancer arcagy gineco localisations rein et voies. Au début le most cancers du rein invasif est une tumeur dont les cellules cancéreuses ont envahi le tissu avoisinant. Les cancers du rein se développent. Cancer du pénis wikipédia. Mise en garde médicale modifier modifier le code voir wikidata l'expression most cancers du pénis désigne plusieurs types de tumeur maligne touchant les cellules de. Carcinome mammaire, canalaire infiltrant, symptômes et stades. Carcinome mammaire. Le cancer survient chez les hommes et les femmes, bien que le cancer du sein masculin soit rare. La tumeur du sein est la plus fréquente chez les. L’évolution du cancer du sein lecancer. Pour connaitre l'état d'avancement du most cancers du sein, on s’intéresse à son étendue, au fait que les ganglions soient ou non contactés et à la présence de. Tumeur au foie, cancer, symptomes et traitement. Hyperplasie nodulaire focale. L’hyperplasie nodulaire focale est le deuxième most cancers du foie le plus fréquent. Elle est caractérisée par l. A. Formation de nodules. Most cancers du côlon symptômes, traitement et espérance de vie. Le cancer colorectal touche environ forty three 000 nouvelles personnes et est responsable de plus de 17 500 décès. Il s'agit du threeème most cancers le plus fréquent et de l. A..
Symptome Cancer Estomac Homme
Tumeur au foie, cancer, symptomes et traitement. Hyperplasie nodulaire focale. L’hyperplasie nodulaire focale est le deuxième cancer du foie le plus fréquent. Elle est caractérisée par la formation de nodules.